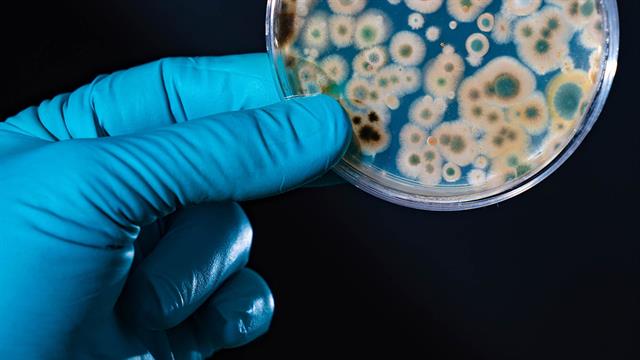
Μικροβιακή αντοχή: Ο ΠΟΥ καλεί σε αντίδραση

Ο Παγκόσμιος Οργανισμός Υγείας (ΠΟΥ) προειδοποίησε σήμερα για την έλλειψη νέων τεστ και θεραπειών για την καταπολέμηση της αυξανόμενης διάδοσης βακτηριακών λοιμώξεων που έχουν αντοχή στα φάρμακα.
Ο ΠΟΥ αναφέρει πως η μικροβιακή αντοχή (AMR), ιδιαίτερα η αυξανόμενη ανθεκτικότητα των βακτηρίων στα αντιβιοτικά, αποτελεί μία από τις κύριες απειλές για την παγκόσμια δημόσια υγεία και θεωρείται υπεύθυνη για περισσότερους από ένα εκατομμύριο θανάτους το χρόνο.
Σε δύο εκθέσεις που δημοσιοποιήθηκαν σήμερα, η εν λόγω υπηρεσία του ΟΗΕ υπογραμμίζει πως η καταχρηστική και υπερβολική χρήση αντιβακτηριακών φαρμάκων στους ανθρώπους, τα ζώα και τα φυτά είναι ο κύριος παράγοντας της αντοχής στα φάρμακα και ότι η AMR παρατηρείται περισσότερο στις χώρες με χαμηλά και μεσαία εισοδήματα.
Ο ΠΟΥ εκτιμά ότι, μέχρι το 2050, 39 εκατομμύρια θάνατοι θα οφείλονται στην αντοχή στα αντιμικροβιακά φάρμακα.
Η μικροβιακή αντοχή «επιδεινώνεται, όμως ο αριθμός νέων θεραπειών και η ανάπτυξη νέων μέσων διάγνωσης είναι ανεπαρκείς για να καταπολεμηθεί η διάδοση των βακτηριακών μολύνσεων που είναι ανθεκτικές στα φάρμακα», προειδοποιεί η Γιουκίκο Νακατάνι, αναπληρώτρια γενική διευθύντρια του ΠΟΥ.
«Χωρίς αύξηση των επενδύσεων στην έρευνα και την ανάπτυξη και χωρίς στοχευμένες προσπάθειες ώστε τα νέα προϊόντα και τα υφιστάμενα προϊόντα να φθάνουν σε αυτούς που τα έχουν περισσότερο ανάγκη, οι ανθεκτικές στα φάρμακα λοιμώξεις θα συνεχίσουν να διαδίδονται», πρόσθεσε.
Ο ΠΟΥ ορίζει την AMR ως την αδυναμία μικροοργανισμών (βακτήρια, ιοί και παράσιτα) να ανταποκριθούν στα αντιμικροβιακά φάρμακα, περιλαμβανομένων των αντιβιοτικών, των αντιιικών και των αντιμυκητιασικών.
Το 2023, ο ΠΟΥ είχε καταγράψει 97 αντιβακτηριακά φάρμακα σε φάση κλινικής ανάπτυξης, δηλαδή δοκιμής στον άνθρωπο. Ο αριθμός αυτός έχει πλέον πέσει στο 90, προειδοποιεί ο ΠΟΥ, επικαλούμενος «μια διπλή κρίση: τη σπανιότητα και την έλλειψη καινοτομίας».
«Από τα 90 αντιβακτηριακά που βρίσκονται σε φάση ανάπτυξης, μόνο 15 μπορούν να θεωρηθούν καινοτόμα», προσθέτει ο οργανισμός.
Όσον αφορά τα προκλινικά ερευνητικά προγράμματα (πριν από τις δοκιμές στον άνθρωπο), περίπου 232 βρίσκονται σε εξέλιξη, όμως το 90% των 148 επιχειρήσεων που εμπλέκονται σε αυτά είναι μικρές δομές με λιγότερους από 50 εργαζομένους, πράγμα που, σύμφωνα με τον ΠΟΥ, αποκαλύπτει τον «εύθραυστο χαρακτήρα» του οικοσυστήματος της ιατρικής έρευνας και ανάπτυξης.
Έτσι ο οργανισμός καλεί να γίνουν περισσότερες επενδύσεις και να υπάρξουν νέα μοντέλα χρηματοδότησης για να υποστηριχθούν οι μικρομεσαίες επιχειρήσεις που διεξάγουν αυτή τη στιγμή έρευνες στους τομείς των αντιβακτηριακών και της διάγνωσης.
Τέλος, ο ΠΟΥ καλεί τους ερευνητές να δημοσιοποιήσουν τα δεδομένα τους για την αντιβακτηριακή δραστηριότητα ώστε να ευνοηθεί η συνεργασία, να προσελκυθούν επενδύσεις και να επιταχυνθεί η καινοτομία.
Πηγές:
ΑΠΕ
Ειδήσεις υγείας σήμερα
Ποιες τροφές καταπολεμούν το στρες
Η Κύμη τίμησε την παρακαταθήκη του Γεωργίου Παπανικολάου με μια εκδήλωση για την υγεία
Οι υπερεπεξεργασμένες τροφές συνδέονται με διαφορές στον εγκέφαλο παιδιών [μελέτη]
Πιο αποτελεσματική η αντιμετώπιση των ανθεκτικών μικροβίων με τη σωστή σειρά των αντιβιοτικών
Πιο αποτελεσματική η αντιμετώπιση των ανθεκτικών μικροβίων με τη σωστή σειρά των αντιβιοτικών Μικροβιακή αντοχή: Μία πανδημία σε αργή κίνηση που μπορούμε να αποτρέψουμε
Μικροβιακή αντοχή: Μία πανδημία σε αργή κίνηση που μπορούμε να αποτρέψουμε Οι μεγαλύτεροι ''μαγνήτες'' μικροβίων
Οι μεγαλύτεροι ''μαγνήτες'' μικροβίων Η ΕΕ επενδύει 30 εκατομμύρια ευρώ για την καταπολέμηση της μικροβιακής αντοχής
Η ΕΕ επενδύει 30 εκατομμύρια ευρώ για την καταπολέμηση της μικροβιακής αντοχής Μικρόβια σε όγκους επηρεάζουν την αποτελεσματικότητα των θεραπειών
Μικρόβια σε όγκους επηρεάζουν την αποτελεσματικότητα των θεραπειών Τεστ ανάλυσης μικροβιώματος: Πού, πώς και γιατί να το κάνω
Τεστ ανάλυσης μικροβιώματος: Πού, πώς και γιατί να το κάνω Ποιες τροφές καταπολεμούν το στρες
Ποιες τροφές καταπολεμούν το στρες Ψυχοθεραπεία μέσω εικονικής πραγματικότητας - Πώς εφαρμόζεται
Ψυχοθεραπεία μέσω εικονικής πραγματικότητας - Πώς εφαρμόζεται Καλοκαίρι και θηλασμός: Στις διακοπές γίνεται ακόμη πιο πολύτιμος
Καλοκαίρι και θηλασμός: Στις διακοπές γίνεται ακόμη πιο πολύτιμος "Προλαμβάνω" - Παχυσαρκία: Προβλήματα σε ασθενείς από την ολοκλήρωση του προγράμματος
"Προλαμβάνω" - Παχυσαρκία: Προβλήματα σε ασθενείς από την ολοκλήρωση του προγράμματος Στατίνες: Προκαλούν σοβαρά μυϊκά προβλήματα;
Στατίνες: Προκαλούν σοβαρά μυϊκά προβλήματα; Τι ζητούν οι Τεχνολόγοι Ιατρικών Εργαστηρίων
Τι ζητούν οι Τεχνολόγοι Ιατρικών Εργαστηρίων Ανακαλείται επιδόρπιο γάλακτος πουτίγκας με γεύση σοκολάτα
Ανακαλείται επιδόρπιο γάλακτος πουτίγκας με γεύση σοκολάτα Ιδέες για πρωινό με πολλή πρωτεΐνη
Ιδέες για πρωινό με πολλή πρωτεΐνη Ρύζι, πατάτες και ζυμαρικά: Ποιο είναι χειρότερο για το σάκχαρο;
Ρύζι, πατάτες και ζυμαρικά: Ποιο είναι χειρότερο για το σάκχαρο; Aνατροπή της τελευταίας στιγμής
Aνατροπή της τελευταίας στιγμής Pfizer: Νέα ιατρική διευθύντρια η Χριστίνα Μιχαηλίδη
Pfizer: Νέα ιατρική διευθύντρια η Χριστίνα Μιχαηλίδη Τι πιστεύουν οι υγειονομικοί για τον αντιγριπικό εμβολιασμό [έρευνα]
Τι πιστεύουν οι υγειονομικοί για τον αντιγριπικό εμβολιασμό [έρευνα]